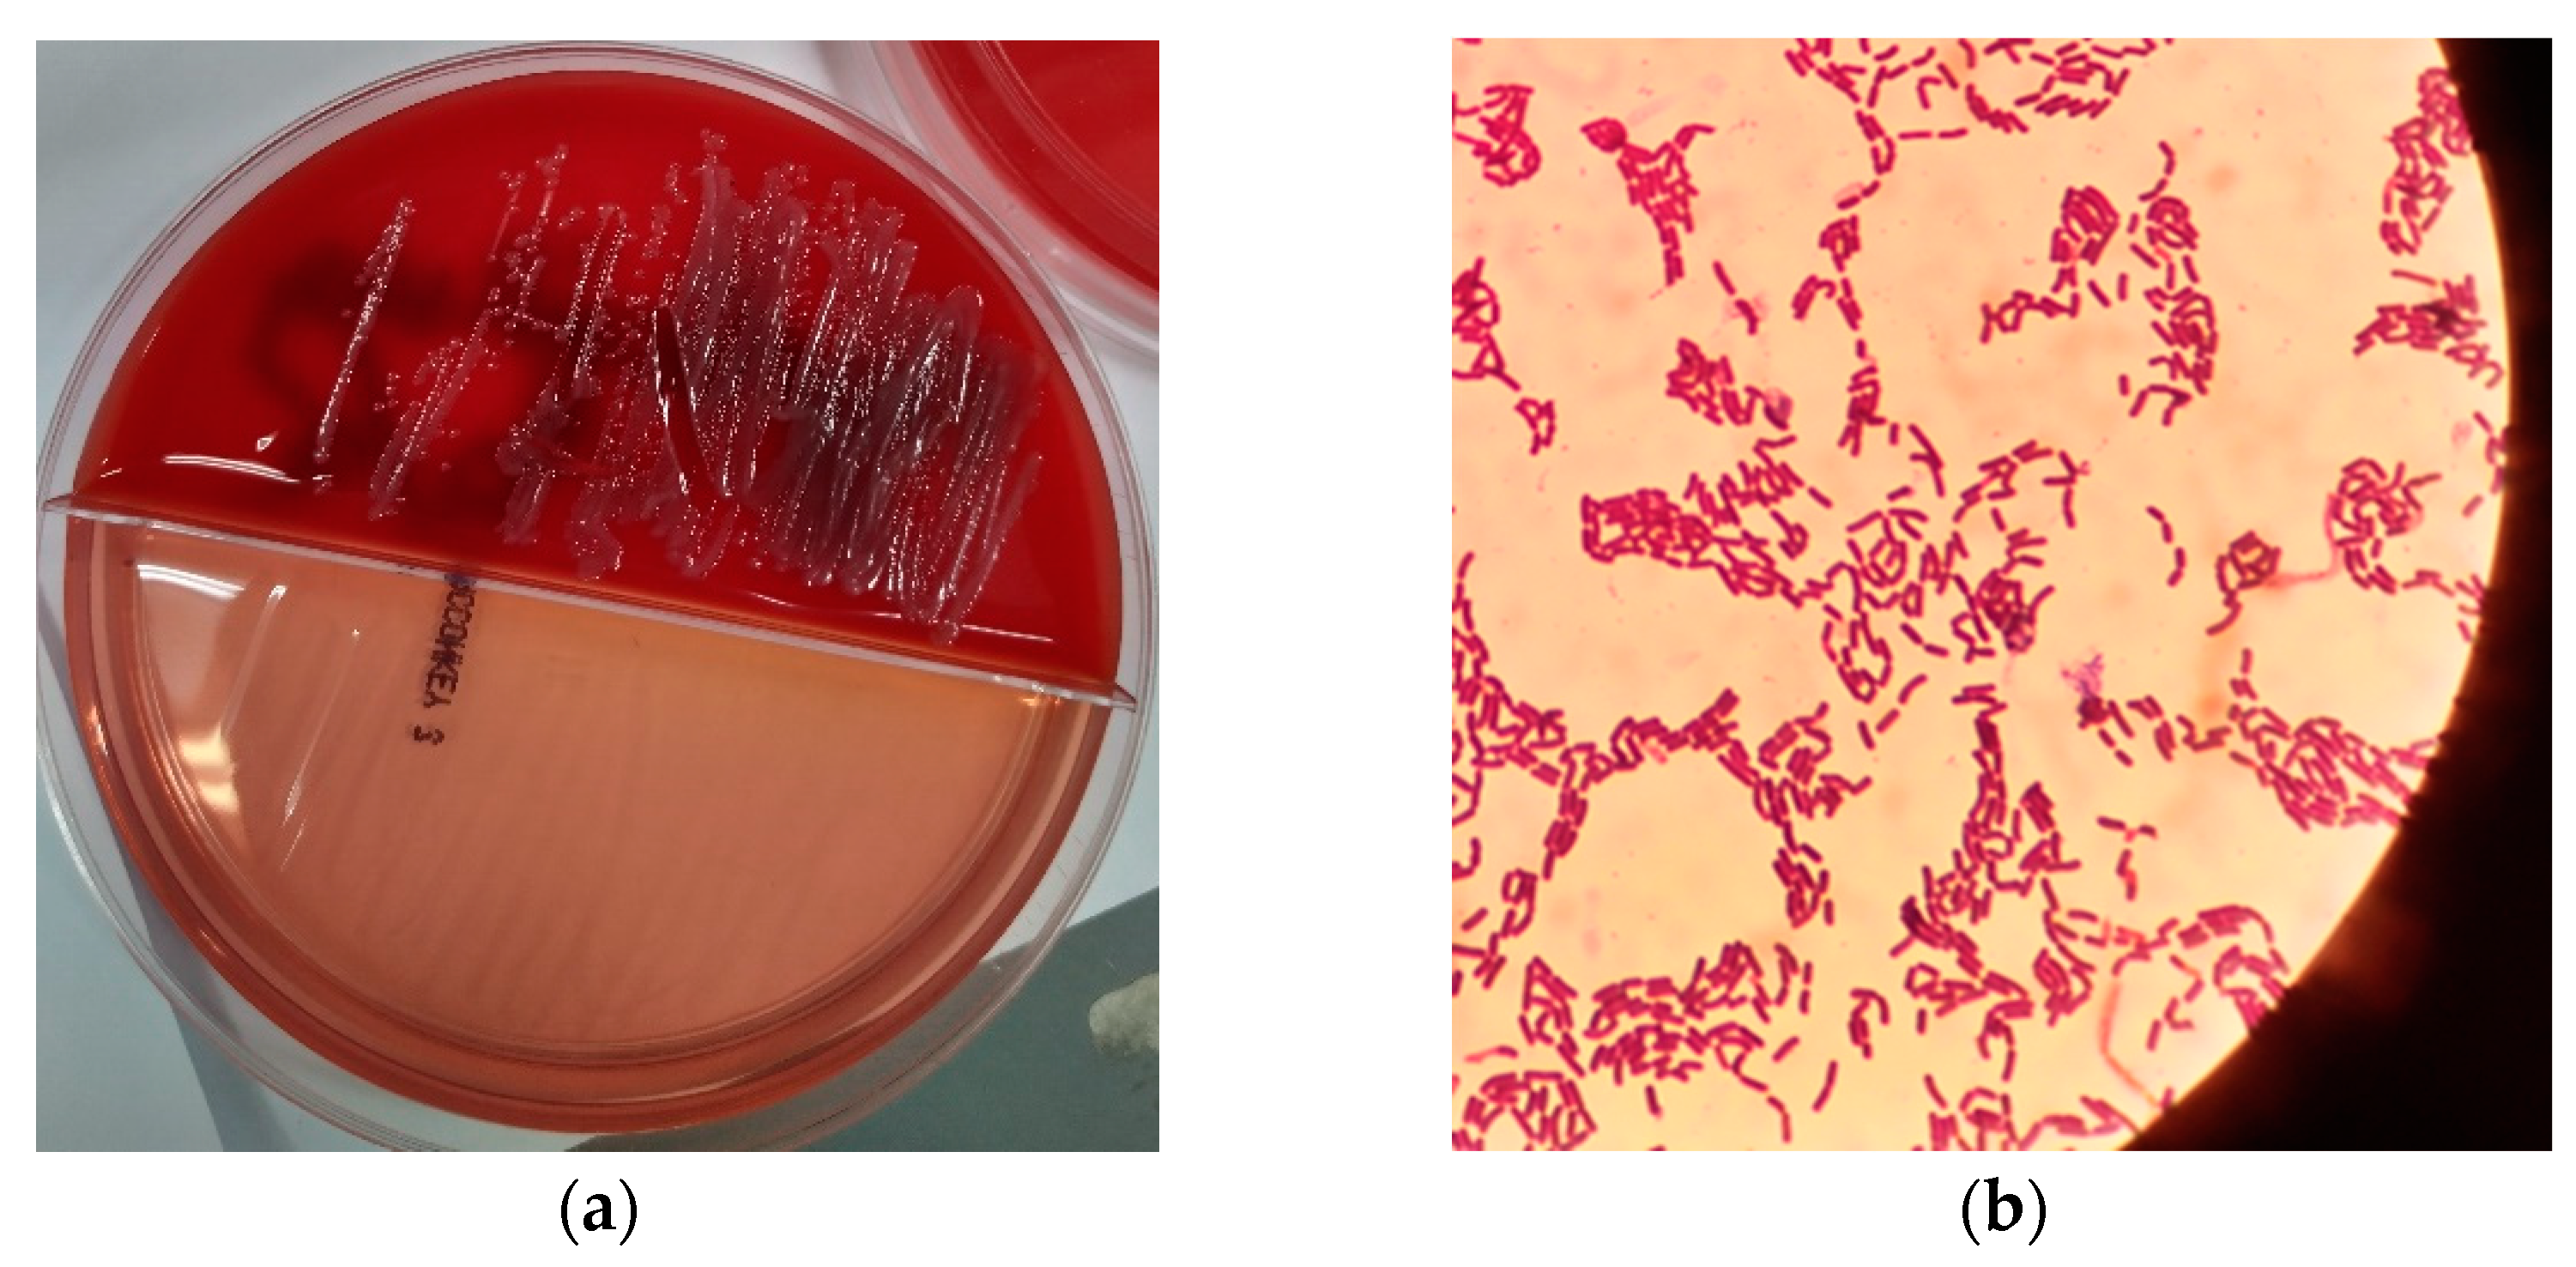

Bacillus simplex as the Most Probable Culprit of Penetrating Trauma Infection: A Case Report
Abstract
1. Introduction
2. Presentation of Case
3. Discussion
4. Conclusions
Author Contributions
Funding
Institutional Review Board Statement
Informed Consent Statement
Data Availability Statement
Acknowledgments
Conflicts of Interest
References
- Society for General Microbiology. Validation list no. 28. Int. J. Syst. Bacteriol. 1989, 39, 93–94. [Google Scholar] [CrossRef]
- International Wound Infection Institute (IWII). Wound Infection in Clinical Practice. Wounds International 2016. Available online: https://www.woundsme.com/uploads/resources/9b549b9d8a74b2c69a7773aa13157376.pdf (accessed on 28 August 2022).
- European Committee on Antimicrobial Susceptibility Testing. Available online: https://www.eucast.org/clinical_breakpoints/ (accessed on 2 August 2022).
- Procop, G.W.; Koneman, E.W. Koneman’s Color Atlas and Textbook of Diagnostic Microbiology, 7th ed.; Wolters Kluwer: Baltimore, MD, USA, 2016. [Google Scholar]
- Tuazon, C.U. Bacillus species. Available online: http://www.antimicrobe.org/b82.asp (accessed on 27 August 2022).
- Drobniewski, F.A. Bacillus cereus and related species. Clin. Microbiol. Rev. 1993, 6, 324–338. [Google Scholar] [CrossRef]
- Pesce, A.; Toccaceli, G.; Andrea, G.D. Uncommon Strain for an Intracranial Infection: Bacillus Simplex as Suspected Cause of Brain Abscess. J. Neuroinfect. Dis. 2016, 7, 209. [Google Scholar] [CrossRef]
- Stenfors Arnesen, L.P.; Fagerlund, A.; Granum, P.E. From soil to gut: Bacillus cereus and its food poisoning toxins. FEMS Microbiol. Rev. 2008, 32, 579–606. [Google Scholar] [CrossRef]
- Taylor, J.M.W.; Sutherland, A.D.; Aidoo, K.E.; Logan, N.A. Heat-stable toxin production by strains of Bacillus cereus, Bacillus firmus, Bacillus megaterium, Bacillus simplex and Bacillus licheniformis. FEMS Microbiol. Lett. 2005, 242, 313–317. [Google Scholar] [CrossRef] [PubMed][Green Version]
- De Bellis, P.; Minervini, F.; Di Biase, M.; Valerio, F.; Lavermicocca, P.; Sisto, A. Toxigenic potential and heat survival of spore-forming bacteria isolated from bread and ingredients. Int. J. Food Microbiol. 2015, 197, 30–39. [Google Scholar] [CrossRef] [PubMed]
- Ramarao, N.; Sanchis, V. The pore-forming haemolysins of Bacillus cereus: A review. Toxins 2013, 5, 1119–1139. [Google Scholar] [CrossRef]
- Beecher, D.J.; Wong, A.C. Cooperative, synergistic and antagonistic haemolytic interactions between haemolysin BL, phosphatidylcholine phospholipase C and sphingomyelinase from Bacillus cereus. Microbiology 2000, 146, 3033–3039. [Google Scholar] [CrossRef]
- Berube, B.J.; Bubeck Wardenburg, J. Staphylococcus aureus α-toxin: Nearly a century of intrigue. Toxins 2013, 5, 1140–1166. [Google Scholar] [CrossRef] [PubMed]
- Oliveira, D.; Borges, A.; Simões, M. Staphylococcus aureus Toxins and Their Molecular Activity in Infectious Diseases. Toxins 2018, 10, 252. [Google Scholar] [CrossRef]
- Hardy, S.P.; Lund, T.; Granum, P.E. CytK toxin of Bacillus cereus forms pores in planar lipid bilayers and is cytotoxic to intestinal epithelia. FEMS Microbiol. Lett. 2001, 197, 47–51. [Google Scholar] [CrossRef]
- Bonifacius, A.; Goldmann, O.; Floess, S.; Holtfreter, S.; Robert, P.A.; Nordengrün, M.; Kruse, F.; Lochner, M.; Falk, C.S.; Schmitz, I.; et al. Staphylococcus aureus Alpha-Toxin Limits Type 1 While Fostering Type 3 Immune Responses. Front. Immunol. 2020, 11, 1579. [Google Scholar] [CrossRef]
- Weber, D.J.; Saviteer, S.M.; Rutala, W.A.; Thomann, C.A. In vitro susceptibility of Bacillus spp. to selected antimicrobial agents. Antimicrob. Agents Chemother. 1988, 32, 642–645. [Google Scholar] [CrossRef]
- Ikeda, M.; Yagihara, Y.; Tatsuno, K.; Okazaki, M.; Okugawa, S.; Moriya, K. Clinical characteristics and antimicrobial susceptibility of Bacillus cereus blood stream infections. Ann. Clin. Microbiol. Antimicrob. 2015, 14, 43. [Google Scholar] [CrossRef] [PubMed]
- Adimpong, D.B.; Sørensen, K.I.; Thorsen, L.; Stuer-Lauridsen, B.; Abdelgadir, W.S.; Nielsen, D.S.; Derkx, P.M.; Jespersen, L. Antimicrobial susceptibility of Bacillus strains isolated from primary starters for African traditional bread production and characterization of the bacitracin operon and bacitracin biosynthesis. Appl. Environ. Microbiol. 2012, 78, 7903–7914. [Google Scholar] [CrossRef] [PubMed]
- Wong, M.T.; Dolan, M.J. Significant infections due to Bacillus species following abrasions associated with motor vehicle-related trauma. Clin. Infect. Dis. 1992, 15, 855–857. [Google Scholar] [CrossRef]
- Croce, O.; Hugon, P.; Lagier, J.C.; Bibi, F.; Robert, C.; Azhar, E.I.; Raoult, D.; Fournier, P.E. Genome Sequence of Bacillus simplex Strain P558, Isolated from a Human Fecal Sample. Genome Announc. 2014, 2, e01241-14. [Google Scholar] [CrossRef] [PubMed]

Publisher’s Note: MDPI stays neutral with regard to jurisdictional claims in published maps and institutional affiliations. |
© 2022 by the authors. Licensee MDPI, Basel, Switzerland. This article is an open access article distributed under the terms and conditions of the Creative Commons Attribution (CC BY) license (https://creativecommons.org/licenses/by/4.0/).
Share and Cite
Xaplanteri, P.; Serpanos, D.S.; Dorva, E.; Beqo-Rokaj, T.; Papadogeorgaki, E.; Lekkou, A. Bacillus simplex as the Most Probable Culprit of Penetrating Trauma Infection: A Case Report. Pathogens 2022, 11, 1203. https://doi.org/10.3390/pathogens11101203
Xaplanteri P, Serpanos DS, Dorva E, Beqo-Rokaj T, Papadogeorgaki E, Lekkou A. Bacillus simplex as the Most Probable Culprit of Penetrating Trauma Infection: A Case Report. Pathogens. 2022; 11(10):1203. https://doi.org/10.3390/pathogens11101203
Chicago/Turabian StyleXaplanteri, Panagiota, Dimitrios S. Serpanos, Ellie Dorva, Tatiana Beqo-Rokaj, Eleni Papadogeorgaki, and Alexandra Lekkou. 2022. "Bacillus simplex as the Most Probable Culprit of Penetrating Trauma Infection: A Case Report" Pathogens 11, no. 10: 1203. https://doi.org/10.3390/pathogens11101203
APA StyleXaplanteri, P., Serpanos, D. S., Dorva, E., Beqo-Rokaj, T., Papadogeorgaki, E., & Lekkou, A. (2022). Bacillus simplex as the Most Probable Culprit of Penetrating Trauma Infection: A Case Report. Pathogens, 11(10), 1203. https://doi.org/10.3390/pathogens11101203





